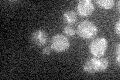
YMR023C
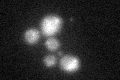
YMR023C

View description
Mitochondrial protein, forms a heterodimer complex with Mto1p that performs the 5-carboxymethylaminomethyl modification of the wobble uridine base in mitochondrial tRNAs; similar to human GTPBP3
Localization:
Intensity:
Fold change:
Significance:
-
C’ GFP library in SD
mitochondria16.67 -
N' NOP1pr-GFP in SD

N/A0 -
N' TEF2pr-mCherry in SD

N/A0 -
N' NATIVEpr-GFP in SD

N/A0 -
N' TEF2pr-VC and Cyto-VN in SD

N/A0 -
C’ GFP library in SD+DTT
mitochondria19.621.17No -
C’ GFP library in SD+H2O2

mitochondria18.751.12No -
C’ GFP library in Starvation Media

mitochondria18.891.13No -
C’ GFP library on the background of Pup2-DaMP

mitochondria -
C’ GFP library on the background of CCT mutant

mitochondria64.57453.8711Yes
